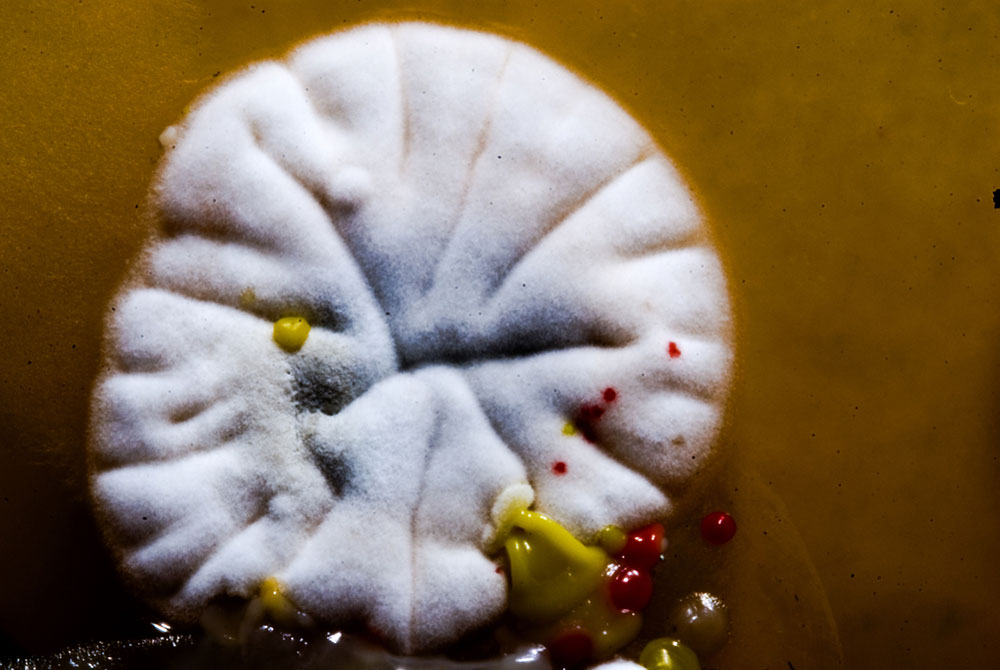

Microscopic Worlds Gallery: Fascinating Fungi
Fancy Fungi
Fungi may not look all that appealing growing on an old, forgotten about piece of bread in the back of your fridge, but up close, these microscopic organisms can be quite eye-catching and even life-saving; take the Penicillium chrysogenum fungus, which is the source of the first antibiotic Penicillin. In fact, the Kingdom Fungi is filled with a slew of amazing organisms, ranging from benign and beneficial to harmful and lethal.
Above, fungi grow alongside bacteria in an agar plate, which is used to culture and observe microorganisms. [Alien Coffee Mug: Get Yours in the SPACE.com store]
Common Colonies

Candida albicansis the most common disease-causing fungus in humans and can be found in most people's bodies, mainly in the mouth and gastrointestinal tract. The fungus, which grows in colonies (like the circular ones shown above), is not harmful if kept in check by our natural gut flora. But overgrowths of the yeast can lead to harmful infections, especially among those with weakened immune systems.
Flowery Fungus

Under a microscope, the fungus Aspergillus niveusresembles a dandelion. This fungus belongs to the Aspergillusgenus, which consists of hundreds of mold species. While most fungi reproduce asexually, in 2005, scientists reported one species of Aspergillus "having sex." [Read full story]
Farming Fungi

A small sample taken from dirty hands and placed in an agar plate led to the patterned bloom of this dark gray fungus, along with a small bacterial colony on the left.
Swaying Strands

The above Chaetomium cochliodes fungus looks like a miniature version of a round, spindly sea urchin.
Shades of Green

This magnified view of a fuzzy fungal colony shows bands of various green colors growing in a tree-ring pattern.
Plant Pathogen

The fungus Trichothecium roseum is a plant pathogen that is responsible for many plant diseases. For example, it causes "apple scab," a disease that results in the development of dark lesions on an apple tree's fruit and leaves. T. roseumcan be found in soil and on decaying plant material.
Get the world’s most fascinating discoveries delivered straight to your inbox.
Fungal Growths

Another magnified image of mold colonies growing in banded, circular patterns on an agar plate. Depending on the species, fungi can be red, pink, orange, yellow, white, green, brown, black and — of course — gray.
SpongeBob Fungus

In June, researchers at San Francisco State University discovered a mushroom species in the forests of Sarawak, Malaysia, that looks like a bright orange sea sponge and smells vaguely fruity. The researchers named it Spongiforma squarepantsii after SpongeBob SquarePants, because the spore-producing area of the fungus looks like a seafloor carpeted in tube sponges.
To Eat or Not to Eat

White, gray and aqua-tinted fungi can often be found growing on old leftovers. Seeing fungi on your food is a sure sign that it's time to throw it out, but some foods, such as blue cheese, are intended to be eaten with their moldy parts. For example, Camembertand Brie cheeses are made using the fungus Penicillium camemberti, which gives the cheeses their distinctive white outer crusts.
Mold Colonies

Another shot of various mold species growing in colonies alongside each other within an agar plate. Like other types of fungi, mold can develop anywhere there are sufficient nutrients, warmth and humidity.

 Live Science Plus
Live Science Plus





